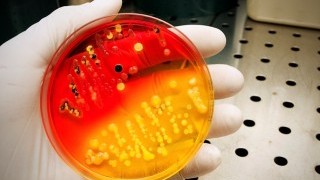

епидемия
-
![]()
Без паника: Как да се информираме правилно за COVID-19
-
![]()
Тайландски ученици изпратиха "сърце" на Китай в подкрепа на борбата с епидемията от коронавирус (ВИДЕО)
-
![]()
Фотографка заснема призрачните улици на китайския Шанхай по време на епидемията от коронавирус
-
![]()
Храните, които укрепват организма, по време на грипна епидемия
-
![]()
7 ценни съвета как да предпазим децата си от зимните инфекции
-
![]()
Предпазване от менингит